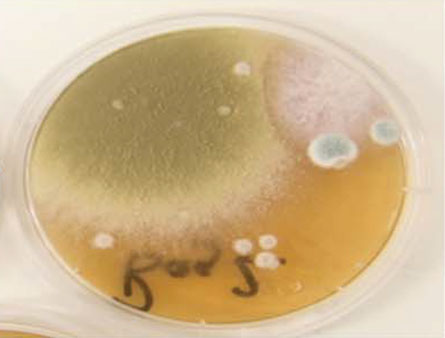

Clean inside those bagpipes — and trumpets and clarinets
Dangerous yeasts and molds can flourish in wind instruments
CLEAN THOSE PIPES Inside the dark, moist interior of bagpipes, fungi can grow and potentially infect the lungs of people who play.
Scott Clark/Flickr (CC BY 2.0)